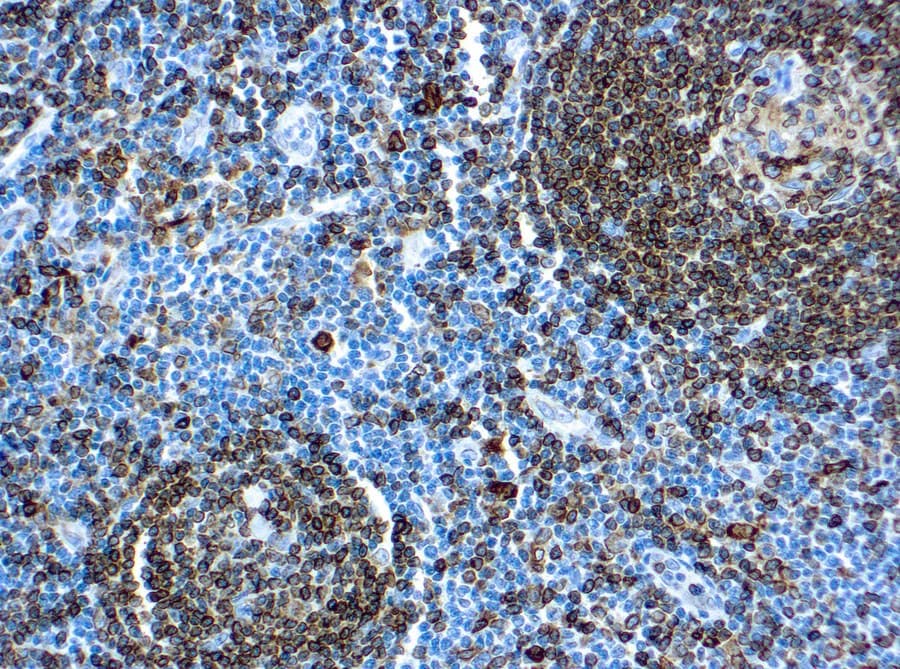

Los anticuerpos anti-Clúster de Diferenciación 74 (CD74) CE/IVD para inmunohistoquímica (IHQ) son herramientas valiosas en hematopatología, ya que apoyan la evaluación de las células presentadoras de antígenos y los procesos asociados a las células B en tejidos fijados en formol e incluidos en parafina (FFPE). El CD74, también conocido como cadena invariante (Ii), es un regulador clave de la presentación de antígenos del MHC de clase II y de la señalización inmunitaria, lo que lo convierte en un biomarcador adyuvante útil en el análisis del tejido linfoide.
Significado biológico del CD74
- El CD74 es una glucoproteína transmembrana de tipo II expresada predominantemente en células B, macrófagos y células dendríticas.
- Funciona como una chaperona para las moléculas del MHC de clase II, regulando su plegamiento, tráfico intracelular y carga de péptidos.
- Forma el complejo CLIP-MHC II, evitando la unión prematura de péptidos durante el procesamiento del antígeno.
- Actúa como receptor para el factor inhibidor de la migración de macrófagos (MIF), activando vías de señalización como NF-κB (a menudo en asociación con co-receptores).
- Contribuye a la regulación inmunitaria y favorece la supervivencia y señalización de las células B.
Utilidad diagnóstica del CD74 en hematopatología
- Se expresa comúnmente en células del linaje de células B y en muchos linfomas de células B, apoyando la evaluación del linaje cuando se utiliza en combinación con marcadores establecidos (p. ej., CD20, CD79a).
- Identifica poblaciones de células presentadoras de antígenos en tejidos linfoides y extranodales.
- Proporciona información complementaria en paneles de IHQ multiparamétricos en lugar de servir como un marcador único definitorio del linaje.
- Los patrones de expresión pueden reflejar la actividad inmunitaria subyacente y se han asociado en entornos de investigación con la biología tumoral y las vías de señalización.
Características clave de los anticuerpos CD74 CE/IVD (IHQ)
- Validados para tejidos FFPE, garantizando la compatibilidad con los flujos de trabajo rutinarios de histopatología.
- Muestran una tinción membranosa y citoplasmática consistente con el tráfico intracelular de CD74.
- Proporcionan una detección sensible de las células presentadoras de antígenos y de los compartimentos ricos en células B.
- Optimizados para la reproducibilidad y el rendimiento estandarizado en aplicaciones diagnósticas CE/IVD.